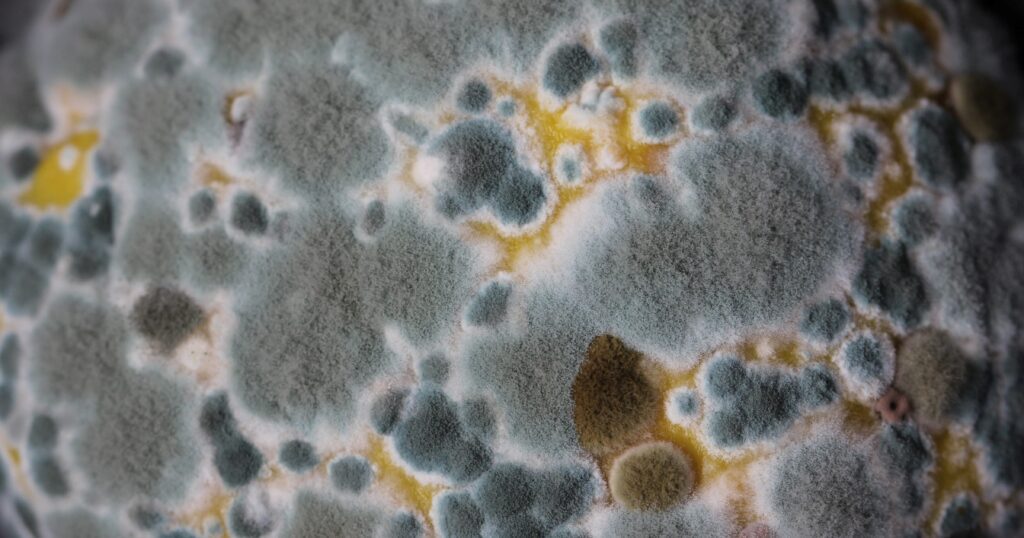
Buđ

Prva stvar koju treba instalirati pri opremanju je pod za kućnu teretanu. Verovatno je najmanje uzbudljiva, ali je to ne čini ništa manje bitnom.
Dodavanje podnih obloga na budžet za kućnu teretanu nije mala stavka, i prvi instinkt je da nam to ni ne treba, jer, pod je već tu. Ne treniramo levitaciju. Retko kome je na pameti podna obloga kada razmišlja o vežbanju. Međutim, upravo je to početna tačka, koju nikako ne smemo zanemariti. Svakako će bilo koja oprema koju nabavite za svoju kućnu teretanu biti postavljena na pod.
I to je logično, zapravo. Svaka aktivnost iziskuje određene zahteve i za podlogu, bez obzira da li se radi o prostoriji za spavanje, pripremu hrane, proizvodnju ili skladištenje. Tako nam i ovde karakteristike poda zavise od namene i zahteva koji će biti stavljeni pred njega.
Ukoliko ne planirate da dižete tegove ili postavljate tešku opremu na pod, zahtevi nisu previše strogi. Ako su vam joga ili pilates, poneka kalistenika, fokus vežbanja, treba vam samo malo mesta gde ćete staviti prostirku. Stvari se menjaju ako planirate da tu držite (i dižete, i spuštate, i ponekad i bacate) velike težine tegova.

A realno, koj’ će vam prostor za vežbanje ako možete da vežbate na vrhu lokalne planine obasjani suncem
Odbrana i zaštita
Bitan parametar o kojem treba da provedete računa jeste zaštita, i to:
- zaštita vas, korisnika, od povreda, toksičnih gasova i neprijatnih mirisa;
- zaštita vašeg okruženja od oštećenja i buke;
- zaštita vaše opreme od oštećenja.
Da bi podna obloga koju stavljajte u svoju teretanu bila sigurna za korisnike, mora biti određene tvrdoće. Tegovi (kao i girje, bućice, medicinske lopte) će vam sasvim sigurno u nekom trenutku ispadati, ponekad i namerno, i nikako ne želite da šipka sa tegovima ili bućica odskoči ka vama kada se to desi.
Pod mora biti dovoljno tvrd, da bi mogao da bude adekvatna podloga za vežbe, jer se ne može kvalitetno vežbati na mekanoj podlozi koja se ugiba pod teretom. Opet, ne treba da bude nešto previše tvrdo, kao beton, jer će vežbanje na takvoj podlozi, naročito ako tu ima i skakanja, biti značajno opterećenje za vaše zglobove. Bilo kakve aktivnosti na takvom podu, posebno ako se na njemu leži, kleči, oslanja na laktove, biće izuzetno neprijatne.
Ako vam teg padne, slučajno ili namerno, podna obloga je tu i da zaštiti pod ispod. Svakodnevno spuštanje (bacanje) velikih težina će ozbiljno oštetiti beton, parket ili laminat, a ni ne treba da objašnjavam šta se dešava ako bacite bilo koju veću težinu na keramičke pločice. Ovo se odražava i na opremu, jer nije dobro ni za tegove da budu stalno bacani na pod (ovo se ne odnosi na bumper tegove, ali o tome drugi put). Većina klasičnih šipki za tegove ne trpi da se stalno bacaju (sa tegovima) na beton.

Ovi tegovi ne lebde u vazduhu; pašće na pod, i biće prilično šokirani tim iskustvom
Podne obloge treba da imaju i određeni nivo trenja, da bi bile dobra podloga kako pri kretanju, tako i da bi vaša oprema i sprave bili stabilni.
Ali čekaj, kakve veze ima pod za kućnu teretanu sa toksičnim gasovima?
Za početak, pomenimo buđ. Toliko prisutna da i ne obraćamo previše pažnje na nju, a opet je opasnija nego što priznajemo. Buđ može prouzrokovati otežano disanje, začepljenje nosa, suvi kašalj, upalu grla i nosa, kao i osip ili nadraženost kože. Najčešće tegobe su mikoze, odnosno trovanja mikotoksinima i alergije izazvane mikoalergenima. Hronično udisanje malih količina ovih otrova može oslabiti imunološki sistem i izaziva različita oboljenja slična gripu. Javlja se na vlažnim mestima, kao i tamo gde je loše provetravanje. Zato bi bilo idealno kad bi svoju teretanu mogli da smestite u dobro osvetljenu i provetrenu prostoriju. Kako to nije uvek opcija, ono što možete je da redovno čistite, i da pazite na podlogu. Izbegavate stare tepihe i itisone kao podnu oblogu. Od vlage, znoja, manjka svetlosti i provetravanja, mogu da se stvore uslovi za pojavu buđi.
Milina…
Pored buđi, postoje i podloge koje ispuštaju toksične gasove. O tome ćemo detaljno pričati kasnije.
Postoje različite opcije podnih obloga koje se mogu naći u teretani. Popričajmo o njima, i o njihovoj nameni.
Beton, beton, samo beton!
Jedna od opcija za kreiranje teretane je korišćenje postojeće prostorije koja se malo ili nimalo koristi. To mogu biti podrumi, tavani, garaže, ili neki deo stana gde nije postavljena nikakva podna obloga (parket npr.). Ovo je primamljivo rešenje, jer, ne zahteva nikakvu pripremu, tvrd je, deluje kao dobra podloga za vežbanje. I to tako deluje dok ne budete odlučili da radite sklekove. Ili trbušnjake. Veslanje. Potisak sa poda. Praktično, bilo koju vežbu gde neki manje zaštićen deo tela dolazi u dodir sa podom (laktovi, kolena, dlanovi). Neke od tih vežbi postaju izuzetno neprijatne kada se rade na betonu. Još ako je i hladnije, neprijatnost se samo uvećava.
Postoje tu i drugi problemi. Mrtvo dizanje ne dolazi u obzir. Oštetićete i pod, i tegove, i ostaviti pukotine i parčiće betona. Kako je podloga izuzetno tvrda, iako je dobra potpora za neke vežbe, skakanje u mestu, i generalno vežbanje, mogu oštetiti zglobove.
Beton jeste dobar da se na njega postavi podna obloga namenjena za vašu teretanu. Ali, ništa više od toga.
Parket ili laminat
Jako davno, dok sam imao izuzetno ograničenu opremu i znanje o vežbanju, koristio sam jeftine bućice, one koje verovatno mogu u svakom većem supermarketu da se nađu. Zapravo, jedna šipka, i par ploč(ic)a. Mislim da ukupno nije bilo više od 7,5 kg opterećenja. Jednom sam bio nepažljiv, i ispustio tu bućicu tokom vežbanja. Od tada je ostalo udubljenje u parketu koje postoji i dan danas (taktički prekriveno tepihom odavno).
Parket, kao i laminat, imaju neke prednosti u odnosu na beton. Manje su osetljivi na hladnoću, nisu hrapavi, i, iako tvrdi, manje su problematični za vaše zglobove. Ipak, i dalje su neprijatni za laktove i kolena, a bilo kakva veća težina će ih trajno oštetiti.
Zaključak je, mora da se stavi neka podna obloga preko postojeće betonske ili drvene, a to ne mogu biti stari tepisi i itisoni zbog buđi. Hajde da vidimo šta je još u ponudi.
EVA ‘puzle’ kao pod za kućnu teretanu
Prva i (naizgled) najprimamljivija opcija na koju ćete naići jesu puzzle EVA podloge. Ovo je najjeftinija i najrasprostranjenija opcija. Takođe, ima izuzetno ograničenu primenu. Meka je, i ne pruža gotovo nikakav oslonac pod nogama, jer se ugiba. Ovo postaje jako bitno kod vežbi kao što su čučnjevi, jer, poslednje što želite jeste nedovoljno stabilna površina dok imate trocifren broj kilograma na leđima. Eliminacija buke je slaba, a trajnost ovih ploča u uslovima eksploatacije u uobičajenim uslovima teretane nikakva. Vrlo će se brzo istrošiti na mestima gde se najviše koristi, a u slučaju pada, ili čak spuštanja, teškog predmeta (tega, na primer) trajno će se oštetiti. Isto važi i ako na takvu podlogu postavite neki od teških predmeta, kao što je kavez ili kardio oprema.

Ove podloge nisu potpuno beskorisne. Ako postoji deo teretane koji je trajno namenjen za nešto kao joga ili pilates, dobra je solucija, jer štiti vaša kolena i laktove, a u ovakvim vidovima vežbanja, opterećenje nije tako značajno. Ali, za bilo šta ozbiljnije od toga vas neće usrećiti.
Gumene podne obloge su najlogičnije rešenje, jer zadovoljavaju većinu zahteva o kojima smo pričali. Međutim, i tu postoji nekoliko parametara na koje treba obratiti pažnju. No, da ne bih sada previše gnjavio o tome, u sledećem tekstu pročitajte detalje o tome kako kupiti kvalitetnu podnu oblogu za vašu kućnu teretanu.








